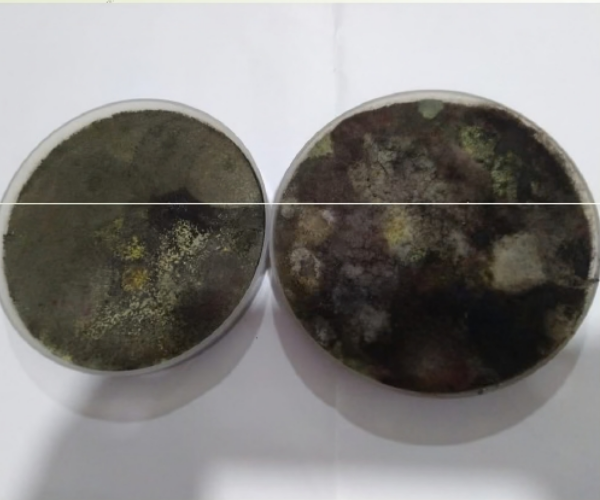

Agriculture Matter to the Future of Development.
Agriculture Matter to the Future of Development.

We only grow the best organic and agriculture products in our farms

Our Introduction
Sustainable, eco-friendly, and science-driven solutions.
We specialize in the manufacturing of biofertilizers and biopesticides, developed from naturally isolated microbial cultures sourced from soil and biological origins. Our patented, result-oriented products are designed to improve soil health, crop productivity, and farm profitability, while significantly reducing dependence on chemical fertilizers and pesticides.
- Scientifically developed and patented microbial products
- Cost-effective inputs for higher farm profitability
- Focus on biodiversity and soil conservation

Patent Certificate
















Email address
bioaxiomagro@gmail.com

Call now
+91 9325289783
Visit Us At -
House No 244, Dharampeth Primary
School, Shankar Nagar, Nagpur,
Maharashtra, India 440010
CIN NO – U20129MH2026PTC464614
Quick Links
Newsletter
Sign up now for weekly news and updates


